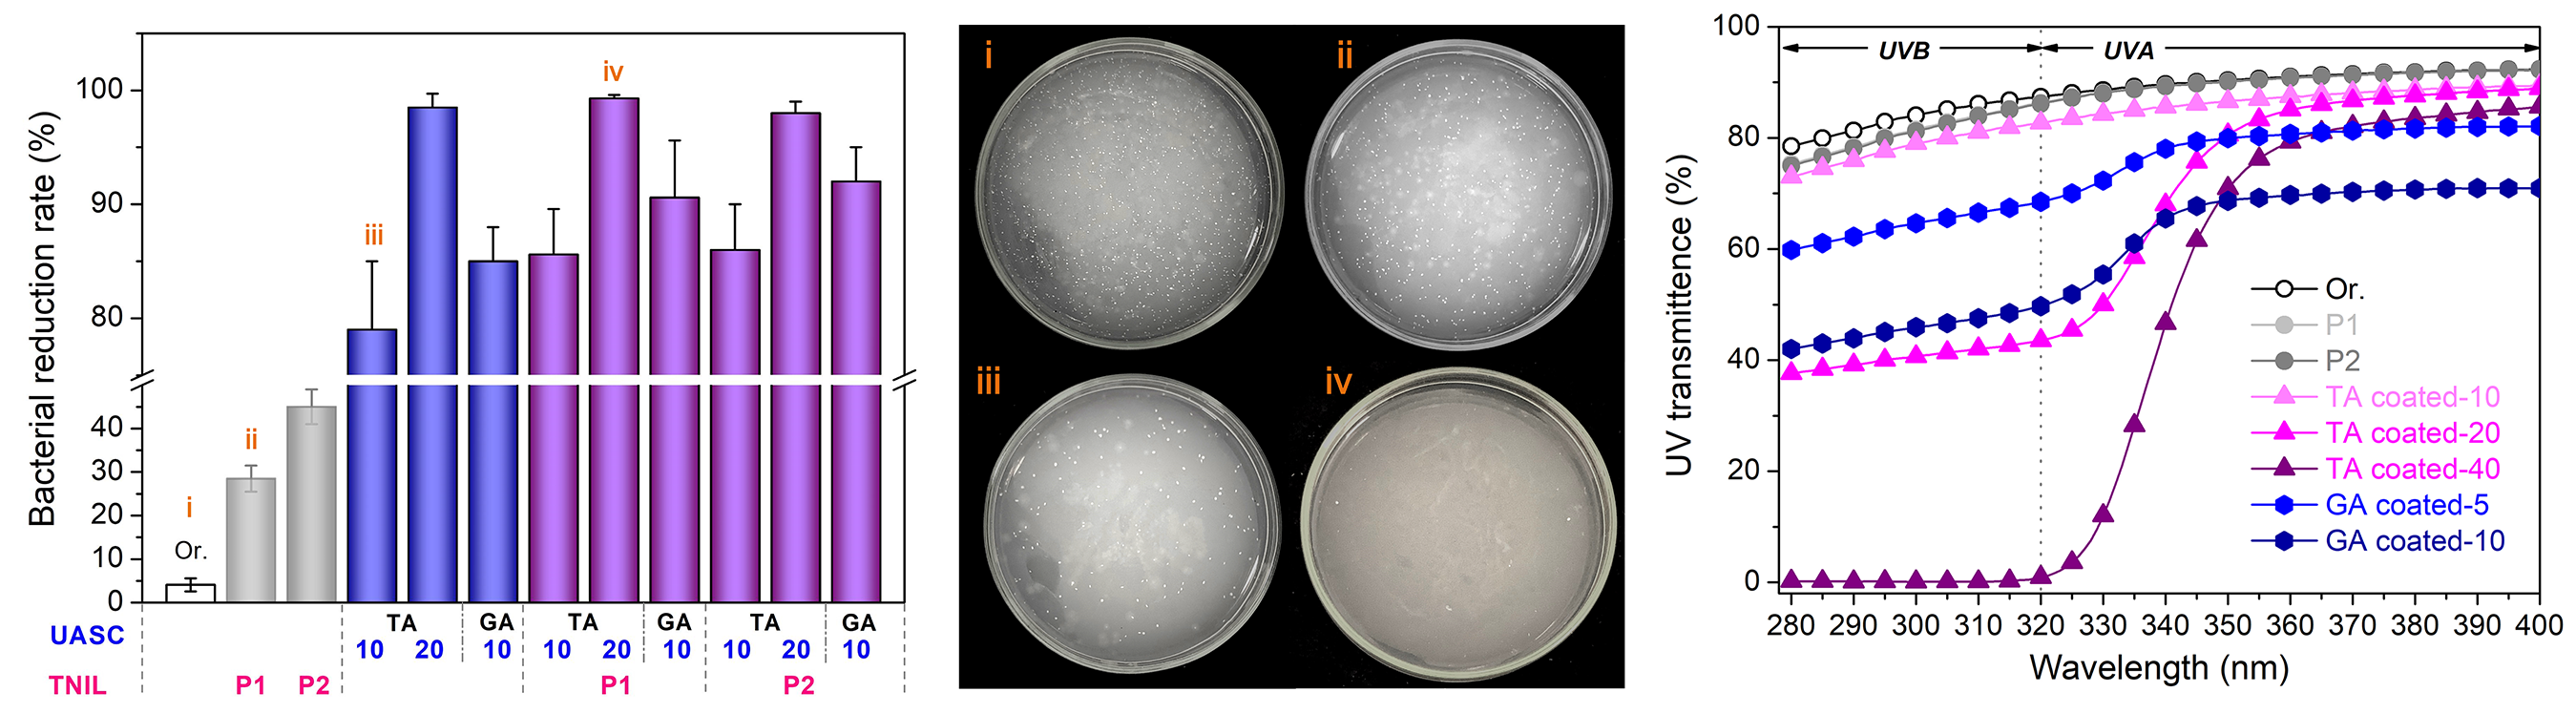

蘇州大學周宇陽博士與愛爾蘭都柏林大學助理教授張楠博士、王文新教授在《ACS Applied Materials & Interfaces》期刊上發表了題為“Toward the Scalable Fabrication of Fully Bio-Based Antimicrobial and UVB-Blocking Transparent Polylactic Acid Films That Incorporate Natural Coatings and Nanopatterns”的文章(DOI: 10.1021/acsami.2c15416)。本課題采用熱納米壓印(Thermal Nanoimprinting Lithography)和超聲霧化噴涂(Ultrasonic Atomization Spray Coating)兩種適用于薄膜的批量化加工技術,分別結合具有微納米錐形孔的陽極氧化鋁模板(Conical Porous Anodic Aluminum Oxide Template)和自制的天然多酚墨水,在聚乳酸薄膜表面批量化構造出全生物基抗菌、低UVB透過的微納米結構(如圖1)。微納米結構與天然多酚涂層的共同作用,賦予了聚乳酸薄膜高效安全的殺菌功能和防紫外線功能,具有在食品包裝、醫用防護等多領域的應用前景。

圖1 利用熱納米壓印和超聲霧化噴涂技術制造抗菌、防紫外聚乳酸薄膜示意圖
首先采用氧氣等離子體對聚乳酸薄膜進行親水化預處理(圖2-1),使后續超聲霧化噴涂中的微米級液滴更易在薄膜表面鋪展;經熱納米壓印后,聚乳酸薄膜表面形成形貌規則的微納米圓臺簇(圖2-2);天然多酚涂層光透性好,保持了聚乳酸薄膜原有的透明性,手指摩擦模擬測試表明該涂層具有一定的耐干、濕摩擦特性(圖2-3)。

圖2 氧氣等離子體處理前后接觸角變化(a),熱納米壓印后表面形貌(b),干濕摩擦耐久測試(c)
在微納米結構與天然多酚涂層的雙重作用下,經修飾的聚乳酸薄膜在24小時內的抑菌率達98%以上,優于僅用微納米結構或天然多酚涂層的抗菌性,且對UVB波段的紫外線具有良好的吸收阻隔功能(圖3);經alamarBlue和活死細胞染色測試,結果表明該天然多酚涂層具有良好的細胞相容性,為其在食品包裝、生物醫療等領域的應用奠定了基礎(圖4)。
圖3 抗菌和紫外線透過測試

圖4 細胞活性測試
原文鏈接:https://pubs.acs.org/doi/10.1021/acsami.2c15416
作者簡介

周宇陽博士目前任蘇州大學紡織與服裝工程學院校優秀青年學者、碩士生導師,主要研究紡織品清潔染整加工技術、功能性高分子材料,已獲國家自然科學基金青年科學基金項目、中國博士后科學基金面上資助項目等多項資助。
http://textile.suda.edu.cn/36/f9/c6545a472825/page.htm
張楠博士是愛爾蘭都柏林大學機械與材料學院助理教授,主要研究聚合物材料微納制造、微流控芯片制造以及基于微流控技術的納米藥物合成及分子診斷;已獲得歐盟瑪麗居里協同創新網絡及愛爾蘭政府項目4.5M歐元支持。張楠博士是第六及八屆聚合物納米復制技術國際會議(PRN2019/2022)主席及微流控工業化國際組織“The Microfluidic Association”理事會成員。
https://www.nanzhangteam.com
- 中國礦大何新建/徐歡團隊 ACS Nano:火場應急防護用多尺度取向耐高溫聚乳酸活性納纖膜 2025-12-24
- 新疆大學吐爾遜·阿不都熱依木教授團隊 CST/IJBM:聚乳酸/聚丙烯/棉稈復合材料調控與性能 2025-09-08
- 青島大學明津法團隊 IJBM:兼具超疏水和光熱效應的聚乳酸纖維氣凝膠用于防冰除冰功能開發 2025-08-17
- 青島大學牛海濤、周華教授團隊 IJBM:天然植物基、無氟多功能涂層織物的構建與性能研究 - 集高牢度超疏水、抗菌與抗氧化于一體 2026-03-13
- 四川大學孫靜/范紅松團隊 ACS Nano:兼顧抗菌活性與細胞保護功能的類酶水凝膠用于細菌性角膜炎中的角膜再生 2026-03-05
- 東華大學朱美芳教授、賈超副研究員等 AFM:抗菌、制冷多功能聚乙烯纖維防護材料 2026-01-06
- 廣西大學林寶鳳團隊 ACS AMI:具有抗菌抗氧化和紫外線防護功能的電子皮膚用于濕度/汗液傳感 2022-12-24